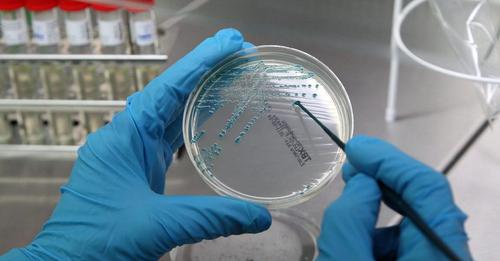

Az Európai Unió területén élő kisebbségek elismerése, jogaik biztosítása…


Benjámin Netanjahu izraeli miniszterelnök szombaton kijelentette, hogy Szájed Haszan Naszrallahnak, a Hezbollah libanoni fegyveres szervezet vezetőjének a likvidálása történelmi fordulópont, amely megváltoztathatja az erőegyensúlyt a Közel-Keleten, ugyanakkor figyelmeztetett a közelgő napok jelentette erőpróbára.


 30 éves a Demokrata – Az évforduló…
30 éves a Demokrata – Az évforduló…



A női boksz után irány a celebkedés?  #mandiner #imanehelif
#mandiner #imanehelif
👉 Tavaly ilyenkor a sportoló adott hírt Facebook-oldalán: https://mandiner.hu/belfold/2023/09/szilagyi-aront-bevalasztottak-a-hiressegek-csarnokaba
Kép forrása: Földházi Árpád / Mandiner